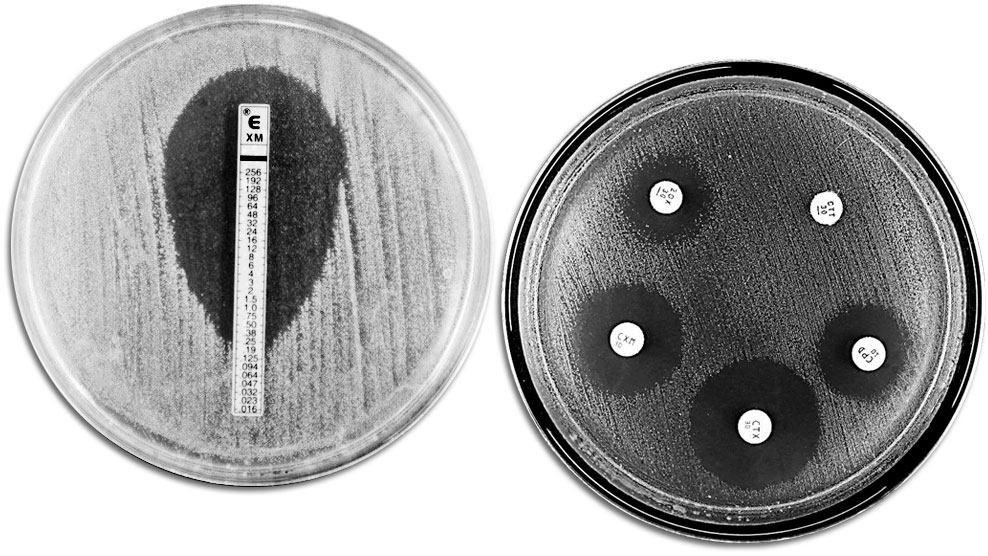
<p>Techniques classiques d'évaluation de la résistance aux antibiotiques. A gauche on voit un E-TEST qui permet de mesurer la concentration minimum d'antibiotique qui empêche la croissance bactérienne. A droite on voit un antibiogramme où on observe différentes zones d'inhibition de la croissance dues aux antibiotiques.</p>

Qu'est-ce-que la résistance aux antibiotiques, pourquoi et quand se produit-elle ?
La résistance aux antibiotiques est le phénomène par lequel une bactérie n'est pas affectée par l'action létale ou inhibitrice d'une molécule antimicrobienne. Ce phénomène se produit habituellement dans la nature depuis des milliers d'années: les antibiotiques sont produits par des bactéries et des champignons dans la nature, dans le but principal d'éliminer leurs concurrents dans une niche écologique déterminée.
Les bactéries qui entrent en contact avec ces antibiotiques développent des mécanismes pour leur résister et pouvoir ainsi coloniser les espaces avec des éléments nutritifs et peu de concurrents.
La plupart des antibiotiques utilisés aussi bien en médecine humaine qu'en médecine vétérinaire ont leur origine dans la nature à partir de ces composés et ce n'est qu'une question de temps que l'utilisation clinique des antibiotiques permette de sélectionner ces mécanismes de résistance si efficaces produits dans la nature .
Les résistances se transmettent-elles entre les différents types de bactéries?
Oui et c'est l'un des gros problèmes. Les bactéries ont généralement trois façons de résister aux effets des antibiotiques: en altérant la cible de l'antibiotique, en détruisant l'antibiotique ou en expulsant l'antibiotique à l'extérieur. En général, ces mécanismes de résistance peuvent être transmis à la fois verticalement et horizontalement, à savoir aux générations suivantes comme à d'autres bactéries de la même espèce ou d'autres espèces.
Une même bactérie peut-elle être résistante à plusieurs antibiotiques?
Les bactéries sont capables d'accumuler les mécanismes de résistance face à de multiples antibiotiques. Cela est particulièrement vrai dans les environnements à haute pression antibiotique comme les hôpitaux ou dans une certaine mesure, les fermes d'élevage. Les bactéries présentes dans ces environnements doivent évoluer pour survivre, et donc s'adapter et capturer des gènes de résistance de l'environnement. C'est le cas, par exemple, dans les élevages, de bactéries environnementales ou de bactéries présentes dans le microbiote d'autres animaux, qui peuvent avoir été récemment introduits dans l'exploitation.
Les gènes de résistance sont-ils omniprésents?
Sans aucun doute. Il s'agit d'un mécanisme naturel de défense contre les molécules antibiotiques naturelles, les gènes de résistance se trouvent dans la nature. En outre, la dissémination de gènes de résistance est un problème mondial, puisque l'utilisation d'antibiotiques, ou leur présence dans l'environnement, a sélectionné favorablement des bactéries avec ces gènes. Dans le monde d'aujourd'hui, où une personne, un animal, de la nourriture ou du matériel peuvent aller d'un point de la terre à un autre à des milliers de kilomètres en quelques heures, il n'est pas absurde de penser, et c'est démontré, que les gènes de résistance se dispersent avec la même facilité. Il est également vrai que certains pays ont des niveaux plus élevés de résistance que d'autres et c'est dû, entre autres, à la mise en place de plans nationaux de lutte contre la résistance aux antimicrobiens.
Comment les résistances sont-elles mesurées/évaluées ?
Les niveaux de résistance peuvent être mesurés par plusieurs techniques. Les techniques classiques comme l'antibiogramme et la microdilution permettent, une fois que l'agent pathogène responsable de la maladie est isolé, déterminer les antibiotiques contre ce qui est résistant ou sensible et connaître les niveaux de résistance. Ces techniques largement utilisées en médecine humaine devraient être mises en œuvre plus dans le monde vétérinaire, car le rapport coût / bénéfice est élevé.
D'autre part, les techniques modernes de biologie moléculaire nous permettent de connaître les niveaux de résistance à des horizons plus larges. En ce moment, notre laboratoire fait partie du projet européen le plus important en médecine vétérinaire pour lutter contre la résistance aux antibiotiques dans la chaîne alimentaire, appelé EFFORT. Ce projet est réalisé d'une manière harmonisée dans 10 pays de l'Union européenne où on a inclus des prélèvements à tous les niveaux depuis les animaux de production (porcs, poulets, dindes, truites et bovins viande) jusqu'aux abattoirs et aux points de vente au public. Grâce à ce projet, nous serons en mesure de connaître les niveaux de résistance aux antibiotiques en Europe de l'élevage à la table (de la fourche à la fourchette).